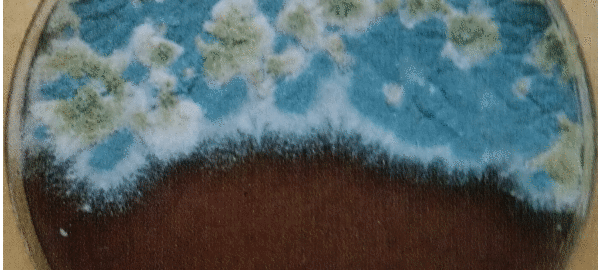

Der medizinische Mykologe ist bei seiner Arbeit für eine Klinik immer an der Frage nach der möglichen Herkunft des Erregers, wie auch am zeitlichen Ablauf der Infektion interessiert. Eine rasche Klärung ist möglich wenn die Überwachung schon vor der Immunsuppression beginnt und nicht erst mit dem Verdacht auf Vorliegen einer Mykose.
Von besonderem Interesse ist dabei die Biotopforschung d.h. die Frage um die Ökologie des Erregers. Bei Aspergillen ist es vorwiegend pflanzliches Material, wie Pflanzen, Humus, Kompost, Erde von Topfpflanzen, Lebensmittel. Aber auch der Aspergillose-Patient unt kontaminierte Gerätschaften können Infektionsquelle sein.

Hier sehen Sie welkende Blütenblätter im Anfangsstadium der natürlichen Kompostierung durch Fadenpilze. Verschieden Aspergillus-Arten

Und hier eine Reinkultur von Aspergillus fumigatus aus Topferde. Bei Kompostierungsstadien kann die Pilzflora bis zu 80% aus Aspergillus bestehen.
Solche Pilz-Entwicklungen können auch in Spitälern entstehen. Meist liegt die Ursache in der falschen Innen- und Aussenarchitektur.
In Krankenzimmern, Fluren, Aufenthaltsräumen und Feuchträumen von Böden, Wänden, Entlüftungsanlagen, Liftschächten können solche Keimbildungen entstehen.

Hier sehen Sie auf der Abbildung Konidienträger von Aspergillus fumigatus ca. 1 1/2 Tage alt. Die an die Luft abgegebenen Konidien (Pfeile) sind 2-3 Mikrometer gross, d.h. es ist inhalationsfähig.
Hier sehen Sie auf der Abbildung Konidienträger von Aspergillus fumigatus ca. 1 1/2 Tage alt. Die an die Luft abgegebenen Konidien (Pfeile) sind 2-3 Mikrometer gross, d.h. es ist inhalationsfähig.
